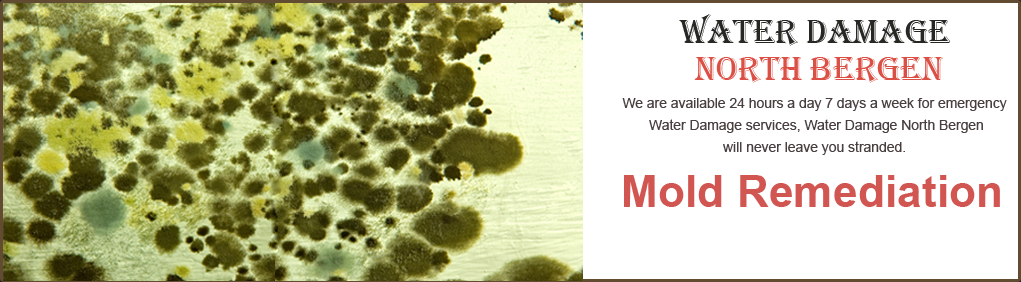
Mold Remediation

Water Damage Restoration Company North Bergen
Water Damage North Bergen serves the North Bergen area and its surrounding zones - we has done for more than 10 years now. Our professional team of certified IICRC technicians will do everything humanly possible to solve your problem; from start to finish. Feel free to contact us for absolutely any of your water damage related issues. You can be sure to get the water damage in your home or business removed as soon as possible.
Some of the benefits you'll experience by using us are:
• Quality workmanship and skill
• Comfort and peace of mind
• Expert representation (when dealing with your insurance company)
• Precision estimating with the industry’s most recognized software
• Detailed walk-through with your insurance adjuster to insure that no items are missed
When you need fast, professional & convenient water damage repair services, call Water Damage North Bergen to assist you. Give us a call today for a free Water Damage Estimate – it’s Quick, Easy and best of all, Risk-Free!
(201) 215-2008
Our Services
- Fire & Smoke Restoration
- Water Damage
- Water Remediation
- Puff Back Clean Up
- Flood Clean Up
- Water Mitigation
- Odor Control
- Mold Removal
Testimonial
The technician was on time with an immediate response. They were very helpful in a time of need. They were straight forward and gave an honest and professional opinion. They were very good and I would recommend them to anyone. A+ performances."
- P. Thomas